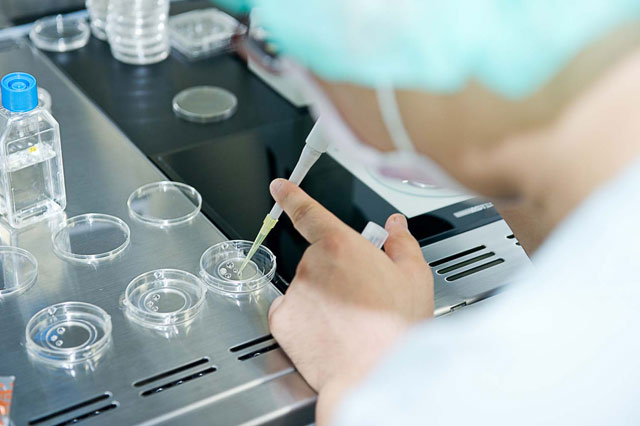

受精
通常の体外受精(IVF)では、卵子に適切な数の精子を振りかけて受精させます。運動精子が十分に回収できない場合や、過去の体外受精で受精障害がある場合には、顕微授精(ICSI)を行います。
体外受精(IVF)
運動精子の数が十分にある場合、過去に受精障害が特にない場合は、卵子に適切な数の精子を振りかけて受精させます。

顕微授精(ICSI)
運動精子が十分に回収できない場合や、過去の体外受精で受精障害がある場合に行います。卵子の細胞質内に精子を1つ人工的に入れて受精させる方法です。実際には細いガラス管に良好な精子を1つ吸引して卵子に挿入し、卵細胞質内に精子を注入します。
※顕微授精は受精方法のひとつであって、卵子が少ないから、なかなか妊娠しないから、といった理由で顕微授精をする必要はありません。体外受精で受精が見られるのに顕微授精をする意味はありません。
※顕微授精の欠点としては、細胞膜の弱い卵子はガラス管の挿入によりダメージを受け受精できない場合があります。

培養
初期胚移植
受精卵は順調に分割すると受精2日目で4分割、3日目で7~8分割になります。この時期の受精卵(初期胚)を移植するのが初期胚移植です。
胚盤胞移植
この移植方法で着床が見られない場合、受精卵が体内で胚盤胞まで育っていない可能性が考えられます。そういった場合には胚盤胞培養を行います。受精卵を体外で5~6日間培養して、着床直前の状態である胚盤胞まで培養して、良好な胚盤胞になったものを移植します。胚盤胞まで発育せず、移植がキャンセルになる可能性もありますが、良好な胚盤胞が移植出来れば、着床率は4細胞期移植の2倍以上と、非常に高くなります。また、クラミジア抗体陽性や、卵管水腫などで機能性卵管障害が疑われる場合にも有効です。
『おち夢クリニック名古屋』の受精培養技術
卵子にやさしいピエゾICSI
『おち夢クリニック名古屋』では、ピエゾICSIを導入しています。これは先端がフラットなガラス管に微小なパルスをかけることによって卵細胞膜に小さな穴を開け、そこから精子を注入する方法です。この方法は、卵子への物理的ストレスが小さくなり、安定した受精成績が得られると考えています。
以前は卵子を固定し、そこに極細の針を刺し入れていました。卵子は、透明帯という膜に守られていますので、それを針で刺し、押し切るような形で精子を注入していきます。そのため針の先端が卵細胞膜に押し込まれたような状態になり、これが卵細胞膜を壊してしまう原因にもなっていました。

ピエゾICSI。
先端がフラットなガラス管に微小パルスをかけて卵細胞膜に穴を開けます。

従来のICSIでは、スパイクのついたガラス管を卵細胞に刺して行います。


卵子紡錘体の観察したうえで行う、安全なICSI
通常のICSIでは卵子の第一極体を12時または6時の方向に固定して行います。これは紡錘体(ぼうすいたい、染色体を含んだ細胞内構造物)が第一極体の直下にあると考えられているからです。ところが実際には第一極体から離れた場所に紡錘体が存在することがあります(我々の検討では、約25%の卵子で第一極体から30°以上離れた場所に紡錘体が存在しました)。通常の顕微鏡では紡錘体を確認することは困難で、ICSIによって紡錘体を破損してしまう可能性もあります。
現在当クリニックでは、Polscopeを用いて紡錘体を確認しています。これは特殊なレンズとフィルターを用いて紡錘体を可視化するもので、紡錘体の位置を確認してICSIを行うことで紡錘体の破損を防ぎます。
また、紡錘体がはっきり確認出来ない場合はまだ卵子が完全に成熟していない場合があります。この場合は1~2時間成熟を待ってから再度紡錘体を確認してICSIを行うことで、より受精率を高めることが出来ます。
さらに、紡錘体の状態から、胚の発育率・妊娠率・流産率・出生後の予後についての予測が出来ないかを現在検討しています。
(現在当クリニックではOosight™ Imaging System、OCTAX polar AIDE™、IX-Robopolarの3種類のシステムを使用して紡錘体の観察を行っています)
<Oosight™ Imaging Systemを用いた紡錘体観察>

紡錘体が第一極体の直下にある場合

紡錘体が第一極体から離れた場所にある場合

通常の顕微鏡での胚の様子

紡錘体が可視化する
アシストハッチング(AHA、着床補助操作)
胚の周囲を覆う透明帯を薄くする、もしくは一部をカットする操作です。胚が透明帯から脱出しやすくなり、着床しやすくなると考えられています。当クリニックではレーザーを用いて、より安全性の高いアシストハッチングを行っています。
この操作は、過去に子宮外妊娠などの卵管性の異常が予想される場合、胚発育が遅い場合、ホルモン調節下の移植法の場合などに着床率を向上させることができます。

初期胚のAHA。透明帯を薄くします。

胚盤胞のAHA。透明帯の一部をカットします。

AHA後に回復培養を行い、カット部分から胚盤胞が半分ほど脱出してきた状態。
先進医療 ~保険治療プラスαの医療技術~

大切な胚をお預かりするクリニックの心臓部
当クリニックでは、胚培養士が卵子・胚のご説明の際に直接患者様にお会いさせていただいておりますが、培養室内の様子や業務の手技等は衛生管理上直接ご覧いただくことができません。そこで、当クリニックの心臓部である培養室の充実した高度な設備、非常に繊細な手技をご紹介したいと思いますので、ぜひご覧ください。

顕微授精
ICSI dish準備

PIEZO ICSI

ガラス化凍結

胚凍結タンク投入

胚凍結タンク投入

タイムラプス

研究室

研究室

精液検査

培養液準備

検卵の様子

卵子の裸化




